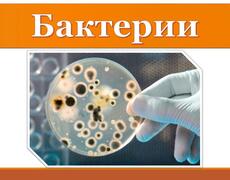

Презентация "Антропогенез"

Презентация по биологии ознакомит учащихся с положением человека в системе животного мира, укажет важнейшие движущие силы антропогенеза. Поможет усвоить основные стадии антропогенеза. Данная презентация даст понятие о человеческих расах, и в частности, о распространении человека по Земле. Презентация оформлена соответствующими фотографиями.
Поделитесь презентаций в соц. сети, нам будет приятно и это стимул для команды работать над новыми материалами. Скачать презентацию
Похожие презентации

Презентация посвящена изучению особенностей строения растительной…
Скачать презентацию
Работа полностью раскрывает понятие клетки, как необходимого…
Скачать презентацию
Все биохимические процессы в клетке должны протекать слажено…
Скачать презентацию
Цель презентации изучить строение головного мозга. В работе…
Скачать презентацию
Данная работа в первую очередь предназначена для проверки…
Скачать презентацию
В данной работе рассмотрены такие вопросы: Фитонциды - природный…
Скачать презентацию